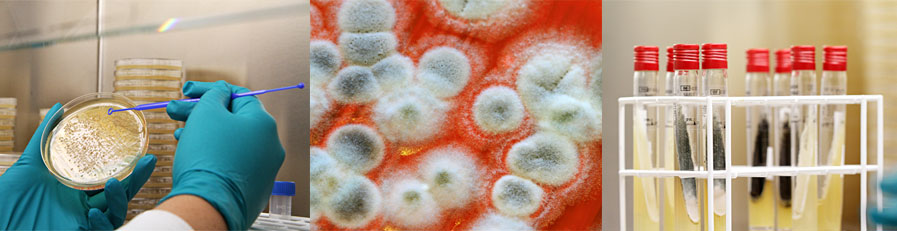
BioPreserv laboratoire de biologie à Grasse

BioPreserv vous offre études et prestations de service grâce à un laboratoire de biologie, de chimie analytique et un savoir-faire réglementaire.
Maîtrisez la qualité de vos produits et améliorez vos procédés de production. Nos domaines de compétences sont les cosmétiques, les détergents, les matériaux architecturaux et les produits vétérinaires. Nous intervenons également pour tout autre secteur d'activité selon vos problématiques spécifiques.
Industriel
- Réaliser des audits « hygiène industrielle » : compétences microbiologie.
- Contrôlez vos produits finis et matières premières: compétences en microbiologie / chimie.
- Sécurisez votre approche réglementaire : compétences en réglementation.
- Formulez vos échantillons R&D : compétences en formulation.
Distributeur
- Développez le support technique pour vos clients : compétences chimie / microbiologie.
- Validez l'efficacité d'un produit par des tests en laboratoire indépendant : compétences en chimie / physico-chimie / microbiologie.
- Proposez des contrôles microbiologiques et chimiques post-production : compétences en microbiologie / chimie.
- Réalisez des audits d'hygiène industrielle pour vos clients : compétences en microbiologie/ expertise d'audits.
Producteur de biocides
- Absorbez les pics d'activité en réalisant les tests d'efficacité avec un laboratoire indépendant.
- Testez l'efficacité de principes actifs pour le développement de nouveaux produits ou l'enregistrement réglementaire (Règlement biocide BPR)
- Aidez vos clients à formuler les produits finis avec l'expertise d'un laboratoire indépendant.
Responsable de produits cosmétiques
Vous êtes créateur, fabricant, revendeur, metteur sur le marché: avec BioPreserv,
- Sécurisez les Dossiers Information Produits (dossiers cosmétiques) : constitution « clé en main » ou « à la carte » ; enregistrez vos produits sur le portail de notification CPNP : compétences et expertise en législation / réglementation.
- Criblez, optimisez vos prototypes R&D par l'intermédiaire d'un laboratoire indépendant agréé CIR : compétences en réglementation / chimie / microbiologie.
- Contrôlez vos produits finis et matières premières en condition BPL : compétences en microbiologie / physico-chimie.




